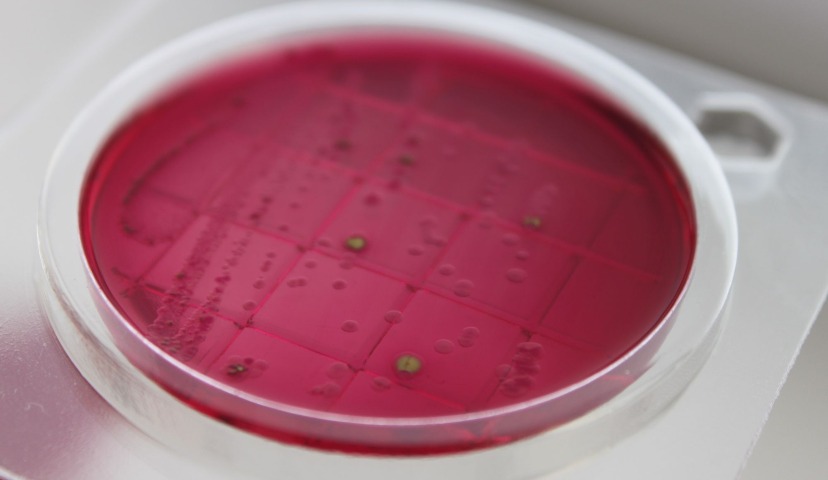
Микробиологические экспресс-тесты «Петритест» – быстрота и эффективность

Микробиологические экспресс-тесты «Петритест» – быстрота и эффективность
Жесткие нормативные требования к сырью и готовой пищевой продукции привели к тому, что многие производители проверяют качество сами, не дожидаясь очередного производственного контроля, плановой или внеплановой проверки Роспотребнадзора. Это уменьшает расходы предприятия на проведение лабораторных исследований и, что тоже немаловажно, бережет нервы его руководителей и технологов.
Для проведения такой внутренней самопроверки активно используются микробиологические экспресс-тесты «Петритест» производства саратовского научно-производственного объединения «Альтернатива». Компания прочно заняла свою нишу в узком, специализированном сегменте. Изучение рынка показало, что многие пищевики с успехом пользуются «Петритестами» на своем производстве.
Постараюсь ответить на наиболее распространенные вопросы, которые нам задают.
Про «Петритесты» часто говорят, что это аналоги американских тестов Petrifilm. Почему бы не придумать что-нибудь свое?
Во-первых, это не аналог, хотя сходство, безусловно, есть, как и со многими другими подобными экспресс-тестами – они все круглые. А во-вторых, потому что все придумано до нас, все эти форм-факторы в том или ином виде уже были представлены на рынке.
Если подобные тесты уже есть, почему потребители предпочитают именно ваш вариант?
Тут сработало несколько факторов. Мы не были ограничены временем: наше основное направление – это разработка комплексных пищевых добавок для пищепрома под торговой маркой «Униконс», а микробиологические экспресс-тесты появились позже, как ответ на потребность нескольких постоянных партнеров. Так вот, временем мы были не ограничены, над душой никто не стоял, и мы достаточно много экспериментировали с формой. В итоге после тестов на подложках появились тесты в пробирках (смывы и индикаторы). И сейчас можно выбирать те, которые непосредственно подходят под задачи потребителей.
Кроме того, у нас не статичное производство, где из года в год выпускается одно и то же, а динамичное научно-производственное объединение. То есть мы не остановились на наиболее востребованных тестах для определения БГКП, а стали постоянно расширять ассортимент. Как это происходит? К нам приходят запросы на какие-то тесты, которых у нас до этого не было. Если количество таких запросов растет, мы понимаем, что это не чья-то ежеминутная прихоть, а действительно спрос на рынке, который мы вполне можем удовлетворить. Именно так у нас появились «Петритесты» на определение сальмонеллы, листерий и синегнойной палочки – их не было в изначальной линейке.
Если же рассматривать не цепочку принятия управленческих решений, а сами тесты, то в основном наших партнеров подкупает быстрота получения результата и эффективность.
Что вы имеете ввиду, когда говорите об оперативности и эффективности?
Классические исследования, допустим, на БГКП, занимают не менее 72 часов. А «Петритест» дает возможность узнать результат в четыре раза быстрее, потому что первые результаты можно визуализировать уже через 12-24 часов. Также и с прочими нашими подложками. Индикаторы вообще дают моментальный результат. Именно это и есть суть экспресс-метода – в быстроте.
Кроме того, у используемых нами питательных сред очень высокая чувствительность, которая показывает результаты даже при небольшом обсеменении. Когда мы только начинали, клиенты звонили нам и радовались как дети, потому что всемирно известные тесты ничего не показали, а на «Петритестах» проросла «кишечка», они вовремя ее «поймали» и отладили заново весь технологический процесс.
Как вы справляетесь с конкуренцией в этой сфере?
Конкуренция это прекрасно. Она заставляет двигаться вперед, развиваться, улучшать нашу продукцию и не почивать на лаврах. Если появляются новые экспресс-тесты, мы, конечно, их внимательно анализируем. Но знаете, что мы заметили? В последнее время уже не мы, а за нами тянутся, нас изучают!
А как же гиганты отрасли? Например, некая американская корпорация, которая тоже выпускает микробиологические тесты? Не страшно с ними соперничать?
Давайте смотреть. Во-первых, в этой компании, насколько мне известно, нельзя приобрести небольшое количество тестов (например, штук 10-20), только крупные партии. Таким образом, практически полностью отсекается малый бизнес, которому такая большая партия тестов может и не понадобиться. У нас же спокойно можно заказать коробку «Петритестов», в которой 10 штук, протестировать их на производстве, и дальше уже решать, сколько вам нужно. Кстати, эта возможность привлекает даже учащихся – наши «Петритесты» активно используются в школьных и студенческих проектах.
Про чувствительность я уже упоминал. Кроме того, поскольку это не отечественная компания, дожидаться тестов придется от двух до шести месяцев. За это время на производстве может случиться что угодно! Согласитесь, гораздо удобнее, когда вы можете выбрать удобную вам транспортную компанию и в течение нескольких дней получить необходимые вам «Петритесты».
Да, что-то, безусловно, может измениться. Например, недавно стало известно, что крупная зарубежная корпорация перенесла свое производство в одну из стран Восточной Европы. По некоторой информации, после этого количество рекламаций на ненадлежащее качество продукции увеличилось в разы. Но мы же не будем пользоваться непроверенными данными и слухами? Конечно, нет. Просто НПО «Альтернатива» приложит все усилия, чтобы наши тесты были всегда качественными и надежными.
В заключении хочется отметить, что небольшая, но прочно стоящая на ногах компания «Альтернатива» зарекомендовала себя среди производителей пищевой продукции как надежный партнер. По отзывам пищевиков, разнообразие консервантов «Униконс», микробиологических экспресс-тестов «Петритест» и антисептиков «Септоцил» покрывает самые насущные потребности производителей.
Именно так, по нашему мнению, и нужно развивать отечественный бизнес – не словом, а делом.
НПО Альтернатива
www.petritest.ru; petritest@yandex.ru
+7 903 328 8043
Заказ бесплатных образцов
Автор материала – Ирина Правская, руководитель направления разработки «Константа ИТ» Материал подготовлен совместно с партнером комьюнити по...
В пятницу, 20 марта 2026 года прошел форум АПК 360, где принимало участие много именитых и известных отраслевых деятелей и...
Материал подготовлен совместно с комьюнити Digital4food и Ириной Правской, руководителем направления разработки «Константа ИТ» И вот момент...
Парейдолия - это распространенная зрительная иллюзия, при которой мозг, стремясь распознать знакомые образы, «дорисовывает» базовые...
Новинки Останкино (ТМ "Папа Может", "Останкино", "Коровино") на выставке ПРОДЭКСПО 2026 ...
Коллеги цифровизаторы-интеграторы, айтишники и все умеющие отличать штрих-коды от...
Уважаемые коллеги здравствуйте. скажите пожалуйста кто уже подал заявку на участие в пилотном...
ну или креазот и деготь вам на стол для вашей печени. Фото снято в ноябре 2025...
Здравствуйте. Остаётся щетина после обесволашивания. Пробовали увеличение циклов, замену бил,...
Здравствуйте, уважаемые! Посоветуйте, пожалуйста. Предлагают по 80000 рублей две термокамеры...
Добрый вечер всем. Когда то писал письмо в ВНИИМП по данным книгам, которые они издавали, на...













